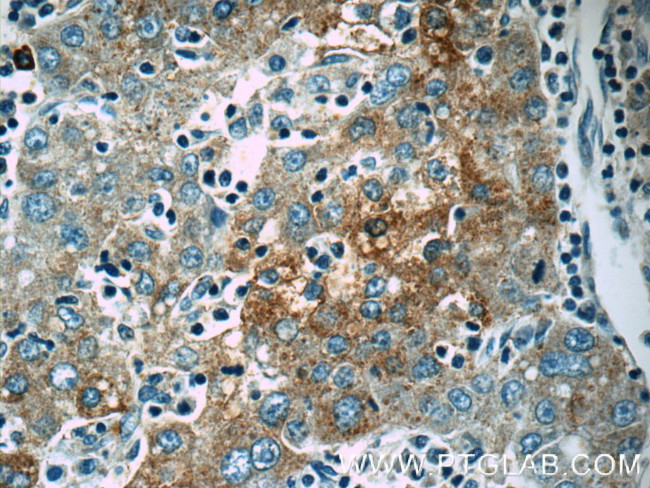
Autotaxin Antibody in Immunohistochemistry (Paraffin) (IHC (P))

Search
Proteintech
Autotaxin Polyclonal Antibody
{{$productOrderCtrl.translations['antibody.pdp.commerceCard.promotion.promotions']}}
{{$productOrderCtrl.translations['antibody.pdp.commerceCard.promotion.viewpromo']}}
{{$productOrderCtrl.translations['antibody.pdp.commerceCard.promotion.promocode']}}: {{promo.promoCode}} {{promo.promoTitle}} {{promo.promoDescription}}. {{$productOrderCtrl.translations['antibody.pdp.commerceCard.promotion.learnmore']}}
产品信息
14243-1-AP
种属反应
已发表种属
宿主/亚型
分类
类型
抗原
偶联物
形式
浓度
规格
纯化类型
保存液
内含物
保存条件
运输条件
产品详细信息
Immunogen sequence: AHRIKRAEG WEEGPPTVLS DSPWTNISGS CKGRCFELQE AGPPDCRCDN LCKSYTSCCH DFDELCLKTA RGWECTKDRC GEVRNEENAC HCSEDCLARG DCCTNYQVVC KGESHWVDDD CEEIKAAECP AGFVRPPLII FSVDGFRASY MKKGSKVMPN IEKLRSCGTH SPYMRPVYPT KTFPNLYTLA TGLYPESHGI VGNSMYDPVF DATFHLRGRE KFNHRWWGGQ PLWITATKQG VKAGTFFWSV VIPHERRILT ILQWLTLPDH ERPSVYAFYS EQPDFSGHKY GPFGPEMTNP LREIDKIVGQ LMDGLKQLKL HRCVNVIFVG DHGMEDVTCD RTEFLSNYLT NVDDI (30-383 aa encoded by B C034961)
靶标信息
The protein encoded by this gene functions as both a phosphodiesterase, which cleaves phosphodiester bonds at the 5' end of oligonucleotides, and a phospholipase, which catalyzes production of lysophosphatidic acid (LPA) in extracellular fluids. LPA evokes growth factor-like responses including stimulation of cell proliferation and chemotaxis. This gene product stimulates the motility of tumor cells and has angiogenic properties, and its expression is upregulated in several kinds of carcinomas. The gene product is secreted and further processed to make the biologically active form. Several alternatively spliced transcript variants encoding different isoforms have been identified.
仅用于科研。不用于诊断过程。未经明确授权不得转售。
生物信息学
蛋白别名: Autotaxin; autotaxin-t; AutotaxinATX; E-NPP 2; ectonucleotide pyrophosphatase/phosphodiesterase 2; Ectonucleotide pyrophosphatase/phosphodiesterase family member 2; Extracellular lysophospholipase D; FLJ26803; LysoPLD; phosphodiesterase I/nucleotide pyrophosphatase 2; phosphodiesterase I/nucleotide pyrophosphatase 2 (autotaxin); plasma lysophospholipase D; unnamed protein product
基因别名: ATX; ATX-X; AUTOTAXIN; ENPP2; LysoPLD; NPP2; Npps2; PD-IALPHA; PDNP2
UniProt ID: (Human) Q13822, (Mouse) Q9R1E6, (Rat) Q64610
Entrez Gene ID: (Human) 5168, (Mouse) 18606, (Rat) 84050